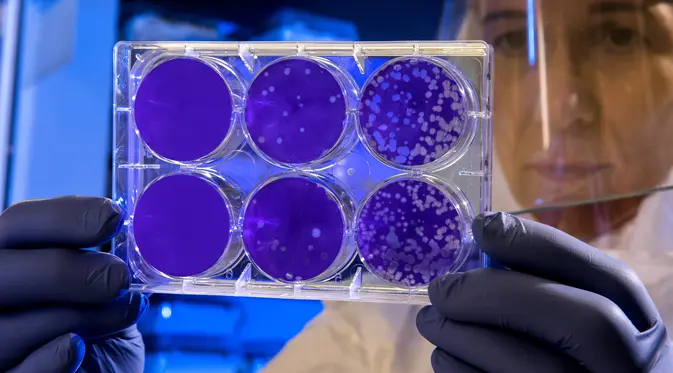

10 Potret Kardashian Bersaudara Bangkitkan Lagi Gaya La Dolce Vita di Acara Pernikahan Kourtney Kardashian dan Travis Barker
Selengkapnya
5 Alasan Pasangan yang Bahagia, Jarang Mengumbar Kemesraan di Medsos
Selengkapnya
Waspada Cacar Monyet yang Kini Merebak di Eropa hingga Australia, Kenali Gejala serta Cara Pencegahannya
Selengkapnya
3 Cara Memakai Lipstik untuk Pemilik Bibir Gelap
Selengkapnya
Melihat Titik Nol Tities Sapoetra dari Koleksi Ground Zero, Inspirasi Monogram Labirint dan TS The Label
Selengkapnya
4 Cara Sederhana Move On dari Mantan yang Paling Dicintai
Selengkapnya
Potret Haru dari Acara Akad Nikah, Tangis Suami Sambut Maudy Ayunda yang Cantik dalam Balutan Kebaya
Selengkapnya
Mengenal Tren Kecantikan PROFHILO® Asal Eropa yang Telah Hadir di Indonesia
Selengkapnya
Manis, Pasangan Kekasih Atlet Menembak Sama-sama Bawa Medali Emas di Sea Games 2021
SelengkapnyaUntuk mengikuti Fimela Share Your Stories, silahkan daftarkan diri Anda dengan daftar menggunakan akun dibawah ini
Daftar dengan Facebook Daftar dengan Gmail Kembali ke Homepage© 2026 Fimela | Share Your Stories All Rights Reserved.